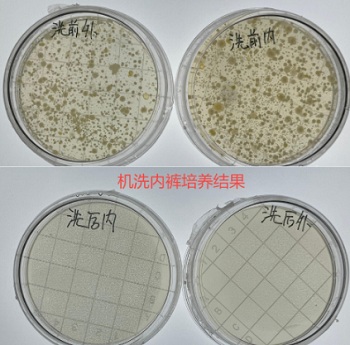

酒店里的洗衣机到底能不能用?
用了会得病吗?
最近
网上非常流行一件事
开钟点房


而是特地把家里不好洗的
公仔、羽绒服、大毛毯都带去酒店
用酒店的洗衣机、烘干机
清洗、烘干



下面我贴心地针对这个问题
来给家人们分析一波
酒店洗衣机到底能不能用?
会不会感染病?
01
洗衣机能不能除菌
用公共洗衣机最担心的就是
不知道上一个人洗的衣服有多脏
会不会污染洗衣机内部
于是我去调查了一下
发现目前市面上新开业的酒店
洗衣房里配的洗衣机 + 烘干机
77.7% 用的是
美某、L 某、海某、T 某 L、某天鹅
这些靠谱的大牌子
奥维云网(AVC)监测数据


正好 2021 年北京市消费者协会
还测评过这 5 个牌子的洗净能力
光是测评的家用版本
除菌率都能达到 99%,除螨率达 100%


有人做过实验,用他穿过的袜子
来对比三种状态的菌落数
没洗 (1.2)、手洗后 (3)、机洗后 (4)
结果手洗袜子的菌落数为 108
机洗袜子没有检出任何细菌


内裤也是!
手洗内裤搓洗 3 分钟 + 冲水 3 遍后
还是残留了比较多的细菌

而机洗的内裤洗完后
几乎没有细菌
更别说酒店里配备的
通常都是商用洗衣机
因为清洗容量大
所以加热功率和紫外线杀菌技术都更强
除菌除螨效果只会更加牛皮

而烘干机也都会有紫外线除菌功能
一边烘衣服一边帮你二次除菌
像衣服上常见的
大肠埃希氏菌和金黄色葡萄球菌
除菌率都能达到 99.9%

对真菌白色念珠菌的除菌率
也在 90.7~99.71% 之间

所以正常来说
不太用担心酒店洗衣机脏!
不过如果害怕别人有啥骚操作
那还是只洗外衣别洗内衣
02
洗衣机本身脏不脏
如果洗衣机久经沙场
那洗衣机过滤网和滚筒内壁死角
很可能会有杂毛、污垢!

好在很多品牌酒店
都有明确要求做筒自洁、定期清洁洗衣机

筒自洁功能
一般是通过高温、高速旋转狠狠去垢的
洗衣机内筒先注入高温热水
再开始高速旋转,用强劲的水流
对洗衣机内筒的各个角落进行冲刷


而且这种高温水流
还能起到杀菌的作用
洗衣机的筒自洁温度达到 90℃
杀菌率能直达 99.99999%


不过还有一件事
奔奔必须给大家通知到位了
在酒店洗完衣服后
干万别到处乱挂!
酒店的屋顶上有这样一个小东西
看起来简直是为挂衣服而生的

但它可不是啥挂衣钩
而是消防喷淋头!
不仅在发生火灾时能迅速喷水灭火
而且挤压、碰撞到喷淋头,也会破裂喷水
像挂衣服就可能会拉坏消防喷淋头
触发喷水


最要命的是
水淹客房不仅仅是淹你这一间
整层走廊、整层客房地板都会被淹
给酒店带来极大的损失



至于最后
是由谁来爆金币呢

好了
本期的科普就到这了
我这迫不及待
去酒店洗我的衣服了!
- END -

